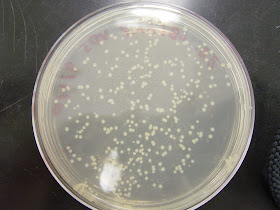

Test for Transformation Efficiency
Determining transformation efficiency (CFU/mg):
Transformation efficiency is the efficiency at which bacterial cells can take up the external DNA and express the gene encoded by it.Transformation technique is used in the recombinant DNA technology inorder to transfer the desired genes / foreign DNA into the bacterial cells for expression.
Transformation efficiency can be calculated from the following equation:
(CFU on control plate/ pg pUC19 DNA used) * ((1 x 10^6 pg)/ug) * Dilution Factor = CFU/mg
CFU is the colony forming units, pUC19 is a vector which is most commonly used in recombinant DNA technology, examples of other vectors include pBR322, pET, etc.
- Use a stock of pUC19 solution (0.01 mg/ml) to determine transformation efficiency.
- Thaw or keep competent cells on ice.
- Add 5 ml (50 pg) control DNA to one polypropylene tube (Falcon 2059) containing 100 ml competent cells. Move the piptette through the cells while dispensing. Gently tap the tube to mix.
- Incubate cells on ice for 30 minutes.
- Heat-shock cells 45 seconds in a 42oC water bath; do not shake.
- Place on ice for 2 minutes.
- Add 0.9 ml of room temperature LB media (no antibiotic).
- Shake at 225 rpm 37oC for one hour.
- Dilute the reaction to 1:400 with LB media (no antibiotic).
- Plate out 100 ml of the above 1:400 dilution on an LB plate containing 100 mg/ml ampicillin.
- Incubate the plate overnight at 37oC.
Determining transformation efficiency (CFU/mg):
Transformation efficiency is the efficiency at which bacterial cells can take up the external DNA and express the gene encoded by it.Transformation technique is used in the recombinant DNA technology inorder to transfer the desired genes / foreign DNA into the bacterial cells for expression.
Transformation efficiency can be calculated from the following equation:
(CFU on control plate/ pg pUC19 DNA used) * ((1 x 10^6 pg)/ug) * Dilution Factor = CFU/mg
CFU is the colony forming units, pUC19 is a vector which is most commonly used in recombinant DNA technology, examples of other vectors include pBR322, pET, etc.
No comments:
Post a Comment